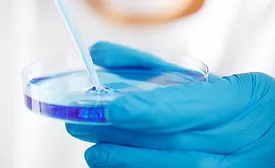
petri dish

Home » Keywords: » investment
Items Tagged with 'investment'
ARTICLES
In a global food and beverage industry under pressure from recalls, regulation, litigation, and consumer expectations, food safety is not just about staying compliant; it is about staying in business
Read More
Food Safety Insights: Food Safety Priorities—Getting ‘Back to Basics'
Pandemic disruptions prevented a greater focus on fundamental issues, to which processors are now returning
October 5, 2023
Top Food Safety Priorities—Where are We Post-Pandemic?
There is still evidence in the economy and in our food industry of a "hangover" from the pandemic that we have not yet fully cleared
August 8, 2023
Risk Culture: How Reducing Complexity Improves the Safety of Consumers, Team Members, and the Company
The way a company approaches its assessment and management of risks has a direct impact on its success
August 7, 2023
Food Safety Priorities—Your Thoughts on FDA's Proposed Reorganization
Food processors weigh in on the proposed reorganization of FDA's Human Foods program and the most important changes the agency should make with this transformation
June 12, 2023
Never miss the latest news and trends driving the food safety industry
Newsletters | Website | eMagazine
JOIN TODAY!Copyright ©2026. All Rights Reserved BNP Media, Inc. and BNP Media II, LLC.
Design, CMS, Hosting & Web Development :: ePublishing